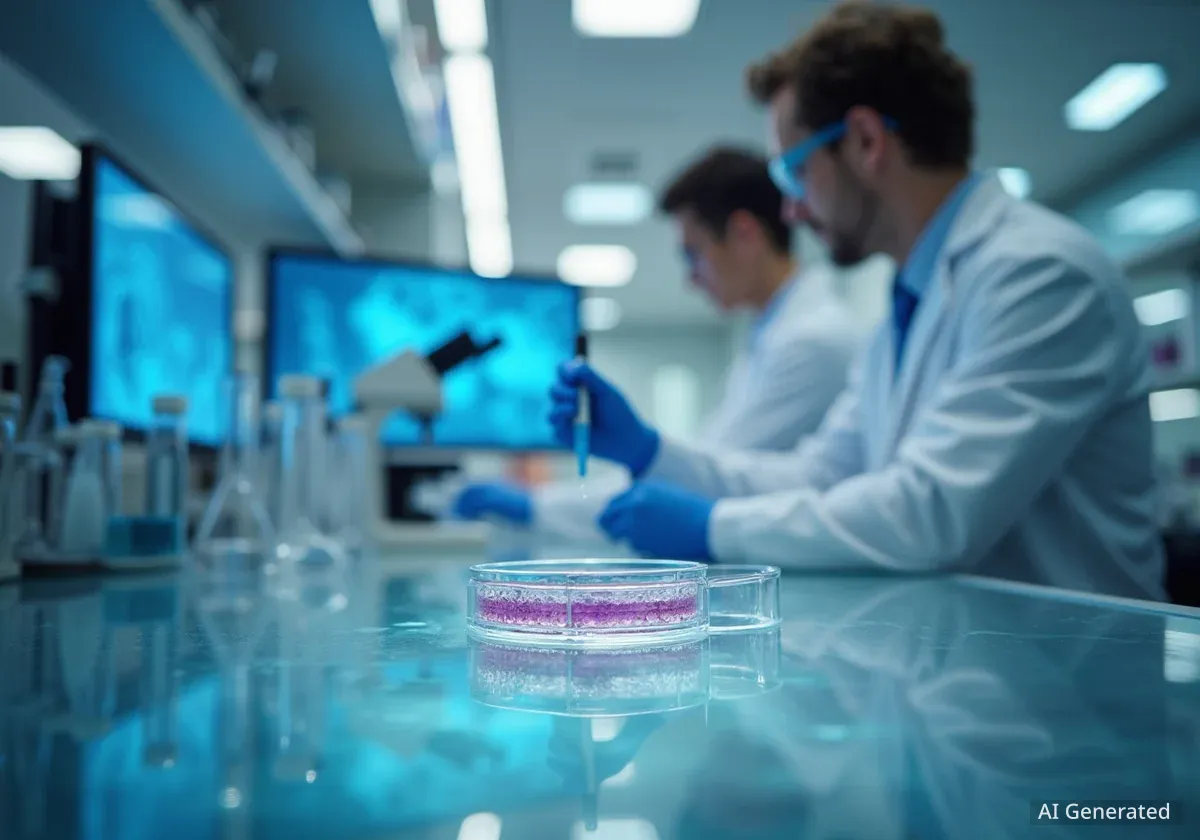
Basler Forschende entwickeln menschliches Knochenmarkmodell

Der Pharmakonzern Roche hat den Grundstein für ein neues Forschungs- und Entwicklungsgebäude am Standort Basel gelegt. Das von den Architekten Herzog & de Meuron entworfene «Bau 12» stellt eine Investition von rund 500 Millionen Franken dar. Ab 2029 sollen hier rund 450 Forschende tätig sein.
Das Wichtigste in Kürze
- Investition: Roche investiert 500 Millionen Franken in den neuen «Bau 12».
- Architektur: Der Entwurf stammt vom renommierten Basler Büro Herzog & de Meuron.
- Arbeitsplätze: Das Gebäude wird ab 2029 rund 450 Forschenden Platz bieten.
- Fokus: Maximale Flexibilität durch modulare Laborstrukturen steht im Zentrum des Konzepts.
Ein starkes Signal für den Forschungsstandort
Mit einer feierlichen Grundsteinlegung hat Roche den offiziellen Baustart für sein neuestes Grossprojekt in Basel markiert. Das 72 Meter hohe Gebäude mit dem Namen «Bau 12» wird im direkten Umfeld der bestehenden Roche-Türme auf dem Nordareal an der Grenzacherstrasse entstehen.
Die Investitionssumme von einer halben Milliarde Franken unterstreicht die langfristige Strategie des Unternehmens für seinen Hauptsitz. Jürg Erismann, Standortleiter von Roche Basel, betonte die Bedeutung des Vorhabens.
«Bau 12 ist ein wesentlicher Bestandteil unserer langfristigen Vision für den Standort Basel. Die Investition von 500 Millionen CHF ist ein klares Bekenntnis zu Basel», erklärte Erismann im Rahmen der Zeremonie.
Das neue Gebäude wird die Forschungs- und Entwicklungskapazitäten des Konzerns erweitern und soll modernste Arbeitsbedingungen für Wissenschaftlerinnen und Wissenschaftler schaffen.
Die Skyline von Roche wächst weiter
Das Roche-Areal in Basel hat sich in den letzten Jahren stark verändert. Mit den Hochhäusern «Bau 1» (178 Meter) und «Bau 2» (205 Meter) prägt das Unternehmen die Stadtsilhouette. Während auf dem Südareal mit einem dritten, noch höheren Turm die vertikale Verdichtung voranschreitet, konzentriert sich die Entwicklung auf dem Nordareal auf mittelhohe Bauten wie den neuen «Bau 12».
Architektur von Herzog & de Meuron
Für die Gestaltung des neuen Forschungsgebäudes zeichnet das international bekannte Architekturbüro Herzog & de Meuron verantwortlich. Der Entwurf für «Bau 12» fügt sich architektonisch in die Reihe der bereits bestehenden Laborgebäude «Bau 6» und «Bau 7» ein.
Charakteristisch ist eine klar strukturierte, vertikal gegliederte Fassade. Damit unterscheidet sich der Neubau bewusst von den historischen Roche-Bauten von Otto R. Salvisberg, wie etwa «Bau 1» und «Bau 2», die durch ihre horizontalen Bänder geprägt sind.
Flexibilität als oberstes Gebot
Ein zentrales Merkmal des neuen Gebäudes ist seine maximale Flexibilität. Die Forschung entwickelt sich rasant, und Laborgebäude müssen sich schnell an neue Anforderungen anpassen lassen. Aus diesem Grund ist «Bau 12» modular aufgebaut.
Die Laboratorien sind so konzipiert, dass Umbauten und technische Anpassungen ohne grosse Eingriffe in die Gebäudestruktur möglich sind. Dieses Konzept ermöglicht es, Forschungsbereiche bei Bedarf schnell neu zu konfigurieren – ein entscheidender Vorteil in einem dynamischen Umfeld wie der pharmazeutischen Forschung.
Zahlen und Fakten zu «Bau 12»
- Höhe: 72 Meter
- Kosten: ca. 500 Millionen CHF
- Fertigstellung: Geplant für 2029
- Kapazität: Arbeitsplätze für ca. 450 Forschende
- Fassadenfläche: Über 10'000 Quadratmeter
Nachhaltigkeit im Fokus
Roche legt nach eigenen Angaben grossen Wert auf die Nachhaltigkeit des Neubaus. Geplant sind unter anderem die Nutzung von Abwärme und Grundwasser zur Energiegewinnung. Auf dem Dach wird eine Photovoltaikanlage installiert, um regenerative Energie zu erzeugen.
Die Planung der Solaranlagen erfolgte mithilfe von Simulationen, um den grösstmöglichen Energieertrag zu gewährleisten. Auffällig ist jedoch der Verzicht auf in die Fassade integrierte Solarmodule. Angesichts der grossen Fassadenfläche von mehr als 10'000 Quadratmetern und moderner Technologien in diesem Bereich erscheint diese Entscheidung zurückhaltend.
Ein weiteres Merkmal ist der hohe Glasanteil der Fassade. Dies wirft Fragen bezüglich des sommerlichen Wärmeschutzes auf. Roche erklärt dazu, dass der Energieeintrag über die Fassade minimiert und gleichzeitig die Nutzung von Tageslicht in den Laboren optimiert werde.
Die Zukunft des Roche-Areals
Mit «Bau 12» setzt Roche die Verdichtung seines Areals in Basel fort. Während die Hochhausentwicklung vor allem auf dem Südareal stattfindet, wo der Grosse Rat kürzlich grünes Licht für einen dritten Turm gab, sind auf dem Nordareal weitere Bauten mit einer Höhe von bis zu 40 Metern möglich.
Die kontinuierlichen Investitionen zeigen, dass der Pharmakonzern langfristig auf den Standort Basel setzt und seine Präsenz in der Stadt weiter ausbaut. Das neue Forschungsgebäude ist ein weiterer Baustein in dieser Strategie und soll die Innovationskraft des Unternehmens für die kommenden Jahrzehnte sichern.